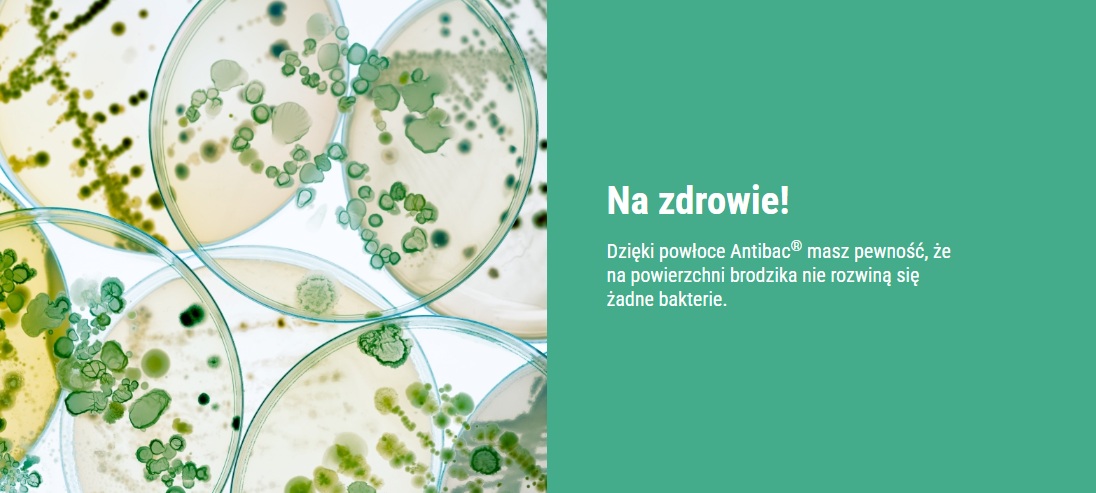

Schedpol Schedline syfon brodzikowy 90mm SDB90PS
-
Załączniki bezpieczeństwa
Załczniki do produktuZałączniki dotyczące bezpieczeństwa produktu zawierają informacje o opakowaniu produktu i mogą dostarczać kluczowych informacji dotyczących bezpieczeństwa konkretnego produktu
-
Informacje o producencie
Informacje o producencieInformacje dotyczące produktu obejmują adres i powiązane dane producenta produktu.
-
Osoba odpowiedzialna w UE
Osoba odpowiedzialna w UEPodmiot gospodarczy z siedzibą w UE zapewniający zgodność produktu z wymaganymi przepisami.SCHEDPOL SPÓŁKA Z OGRANICZONĄ ODPOWIEDZIALNOŚCIĄul. Przemysłowa 2Międzychód-Bielsko,64-400Polska
Dostępność:
w magazynie
-
Kolekcja:
-
Dłuższy bok:
100 cm
-
Krótszy bok:
80 cm
-
Materiał:
Kompozyt Stonicryl
-
Kolor:
Czarny
-
EAN:
5905805741699
Schedpol Schedline Magnific brodzik
Kod produktu: 3SP.M1P-80100/C/ST-M9/C/ST
Kolor: Black Stone 
Wymiary: 100x80 cm
Wysokość: 3,5 cm
Odpływ: 90 mm
W zestawie znajduję się maskownica w kolorze brodzika
Struktura kamienia zapewnia ochronę przed poślizgnięciem i upadkiem
Montaż na posadzce
Materiał: kompozyt Stonicryl®
Technologia: Stabilsound Plus
Wielowarstwowe wzmocnienie konstrukcyjne dna i rantów brodzika oraz powłoka o wysokich właściwościach izolacyjnych
Brodzik można zainstalować w wariancie bezprogowym, co znacząco zwiększa wygodę i bezpieczeństwo użytkowników, szczególnie seniorów oraz osób z ograniczoną mobilnością.
Za pobraniem termin wydłuża się o 4 dni robocze.

Zalety technologii







Schedpol Schedline syfon brodzikowy 90mm SDB90VKO
